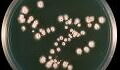
Deutschlandsieg vorausgesagt: Darmbakterien als bisher zuverlässiges EM-Orakel

Als wäre es nicht schon genug, als Teenager eine Lungentransplantation durchstehen zu müssen, sieht sich das junge Mädchen Isabelle Holdaway aus Großbritannien mit einer Mukoviszidose konfrontiert. Das bedeutet, dass nach der Transplantation ihr Körper von Bakterien befallen wird. Ihre Haut, Knochen und Organe entzünden sich und sind mit Abszessen übersät. Die Wunden werden immer größer und die Schmerzen so stark, dass selbst ihre Mutter sie nicht mehr angreifen kann.
Überlebenschance von einem Prozent
Die Ärzte verabreichen ihr Antibiotika, doch ihr Körper nimmt diese nicht an: Er hat eine Antibiotikaresistenz aufgebaut. Dann folgt die harte Diagnose: Ärzte schätzen ihre Überlebenschance auf ein Prozent. Bereits dem Tode geweiht, sind es ihre Eltern, die zu einer neuen Therapie drängen, die bisher noch zu keinen Ergebnisse geführt hat.
Forscher der University of Pittsburgh sind dabei, eine Alternative für Antibiotika zu entwickeln, da viele Menschen an einer Resistenz von Antibiotika sterben. Als die Eltern davon hören, bitten sie die Mediziner, diese Methode an ihrer Tochter durchzuführen.
Die neue Therapieform ist die letzte Hoffnung für die Eltern von Isabelle. Dabei handelt es sich um Bakterienfresser, genauer gesagt Bakteriophagen, die in den Körper des jungen Mädchens eingesetzt werden. Viren werden im Vorfeld von Medizinern soweit manipuliert, dass sie die gefährlichen Bakterien erkennen und bekämpfen.
Und tatsächlich: Diese Bakterienfresser werden ihrem Namen gerecht - sie fressen die Bakterien auf, indem sie ihre DNA in die Zelle einlegen und sich vermehren, bis durch die Phagen die Zellen platzen. Eine Kettenreaktion wird ausgelöst und dabei alle Bakterien im Körper zerstört.
Medizinischer Durchbruch
Die Theorie bestätigt sich: Die bakterienfressenden Viren vermehren sich in dem Körper des jungen Mädchens und die Bakterien sterben. Wie RTL.de berichtet, passiert dies zuerst im Blut und danach in den Wunden - nach sechs Monaten kommt die gute Nachricht: Das Mädchen ist vollständig geheilt, auch ihre Leber und Lunge haben sich erholt und funktionieren besser als vorher.
Für die Medizin bedeutet die Rettung von Isabelle Holdaway eine Sensation und ein Durchbruch für die Therapie mit Bakteriophagen. Sie gibt außerdem Hoffnung für all jene Patienten, die antibiotikaresistent sind. Aber vor allem für das junge Mädchen bedeutet es eines: Mit einer Überlebenschance von einem Prozent hat sie ihr Leben zurückerhalten...